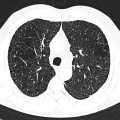

Protocole scanner amiante
- Acquisition en decubitus dorsal sans injection
- +/- Acquisition focale en procubitus si anomalies pleurales ou postéro-basale (éliminer les opacités gravito-dépendantes)
- Analyse en coupes fines et en MIP 5 mm
Parenchyme (asbestose)
Plutôt sous-pleural postéro-basal bilatéral : persistant en procubitus +++ (DDx des opacités gravito-dépendantes)
- Micronodules centro-lobulaires sous-pleuraux (anomalie la plus précoce)
- Lignes courbes sous-pleurales (et réticulations septales) à qqes mm de la plèvre (DDx tassement de tissu pulmonaire devant ostéophyte)
- Verre dépoli, condensations
- Rayon de miel et fibrose (évolution) correspondant à l’asbestose
- Réticulations à raccordement pleural (-spécifique)
Conclusion du compte-rendu pour asbestose : analyse sur 3 niveaux de (carène, veines pulmonaires inférieures, culs-de-sac pleuraux)
- Asbestose absente : que des opacités gravito-dépendantes, aucune lésion interstitielle
- Images interstitielles indéterminées : images interstitielles postérieures en decubitus sans procubitus (en dehors de rayon de miel caractéristique de fibrose)
- Images interstitielles isolées :
- Images interstitielles de localisation autre que postéro-basale
- ou anomalies spécifiques unilatérales strictes
- ou anomalies spécifiques bilatérales sur un niveau de coupe <1cm de hauteur
- ou anomalies spécifiques bilatérales clairsemées sur pls des 3 niveaux de coupes
- Asbestose probable :
- Anomalies spécifiques bilatérales sur un niveau de coupe >1cm de hauteur
- ou anomalies spécifiques bilatérales non clairsemées sur pls des 3 niveaux de coupes
- ou rayon de miel postéro-basal bilatéral sur 1 niveau de coupe
Plèvre
- Plaques pleurales
 (fibrose plèvre pariétale) : quadrangulaire, à bord abrupte +-calcifiée, qq mm à pls cm (correspond à plaques aussi si non quadrangulaire non calcifié mais multiples), tendance à la symétrie, SI POST PERSISTANTE EN PROCUBITUS+++
(fibrose plèvre pariétale) : quadrangulaire, à bord abrupte +-calcifiée, qq mm à pls cm (correspond à plaques aussi si non quadrangulaire non calcifié mais multiples), tendance à la symétrie, SI POST PERSISTANTE EN PROCUBITUS+++
- Antéro-latérale en dehors du muscle triangulaire du sternum (3m au 5m espace)
- Postéro-latérale dans les gouttières costo-diaphragmatiques (6m jusque cul-de-sac pleural), épargne cul-de-sac pleuraux
- Sommet des coupoles diaphragmatiques
- Respect : apex (BK : coiffe apicale), cartilage costal, culs-de-sac costo-diaphragmatiques, piliers diaphragmatiques
- Epaississement plèvre viscérale : séquelle d’épanchement : non spécifique d’amiante
- Sous bord supérieur de la crosse aortique
- Tissulaire, diffus, +- calcifié, atteignant souvent les culs-de-sac, associé à bande parenchymateuse ou pied de corneille ou atélectasie par enroulement
- Pleurésie bénigne : pas de spécificité à l’amiante

Case courtesy of Dr David Cuete,
Case courtesy of Dr David Cuete, 















